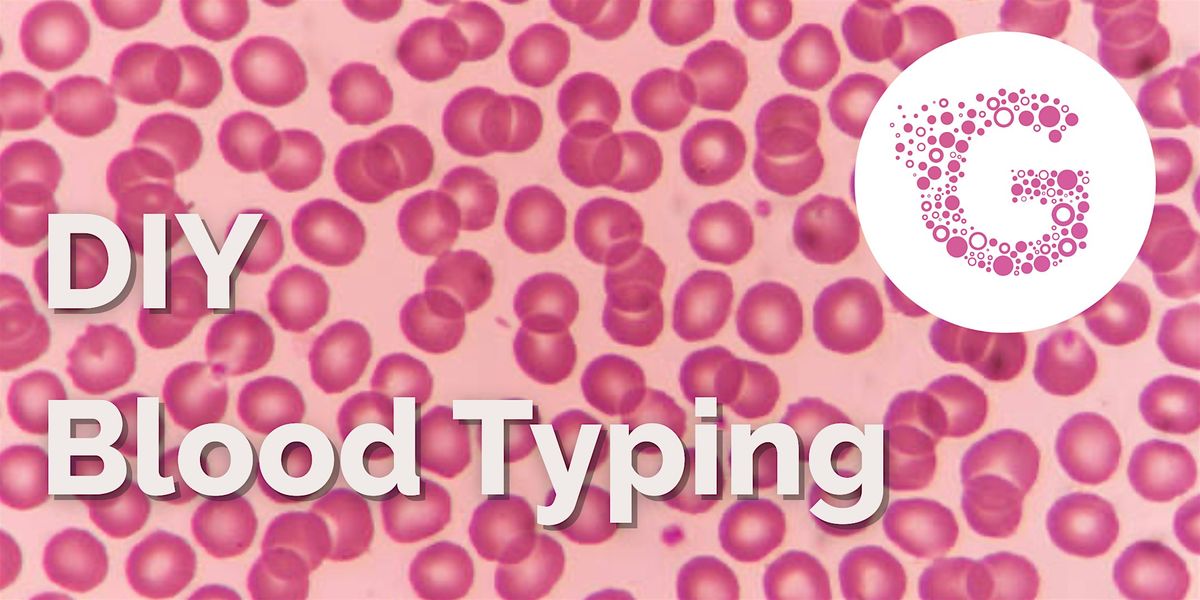

About this Event
What's Your Blood Type? Find out through this experiment!
2-Part Workshop
Session 1: Saturday, February 7, 10:00AM-2:00PM
Session 2: Sunday, February 8, 10:00AM-2:00PM
Discover your blood type and the science behind it in this hands‑on DNA and genetics workshop. Using real lab tools, you’ll learn how scientists isolate DNA, copy genes with PCR, and analyze results to determine your ABO blood type. No prior experience needed, perfect for students, makers, and science enthusiasts in NYC.
Nearly a third of people in the U.S. don’t know their blood type, and it isn’t tested for unless there’s an emergency or a specific medical reason.But your blood type matters. It plays an important role in transfusions, pregnancy, organ transplants, and even disease risk.
By exploring small differences in DNA (called single-nucleotide polymorphisms, SNPs), you'll learn how scientists use restriction enzymes to cut DNA at specific sites and discover whether mutations are present. These mutations affect how sugars are added to the surface of your red blood cells, which ultimately defines your blood type!
In This Workshop, You’ll:
- Extract DNA from your cheek cells
- Make copies of the blood typing gene using polymerase chain reaction (PCR)
- Perform a restriction enzyme digest to identify your blood type
- Run your DNA on a gel to see the results under UV light
- Interpret your band patterns to determine your blood type
COVID-19 Safety Notice:
If you are feeling unwell, suspect that you have been exposed to COVID-19 or have tested positive in the past 7 days, please do not attend and let us know ASAP ([email protected]). If you cancel after our 7-day policy, we cannot refund your ticket, but we can exchange and offer credits toward future classes. If you have signed up for Biohacker Boot Camp, we will automatically transfer your registration to the next month’s dates unless you tell us otherwise.

Meet the Instructor
Brendan Camellato (he/him) is a postdoctoral research scholar at Memorial Sloan Kettering Cancer Center. He was born and raised outside of Ottawa, Canada, and attended the University of Ottawa where he completed a BSc in Biomedical Sciences and an M.Sc. in Cellular and Molecular Medicine. Brendan came to NYC to study at NYU, completing a PhD in Cell Biology. He has experience in cell and molecular biology, synthetic biology, and genome engineering, and has worked with bacteria, yeast, and mammalian cells. He currently works on developing tools for synthetic biology, genome engineering, and molecular recording, and uses them to study developmental and cancer biology. Brendan is very excited about the possibilities that biotechnology can bring to the world, and about helping others better understand these possibilities too. When he’s not engineering biology, Brendan likes to shoot some puck and lay down some groovy beats.
Agenda
🕑: 02:00 PM - 06:00 PM
Session 1
Info: In this session, you'll swab your cheeks and extract DNA from your cheek cells. Then you will set up a polymerase chain reaction (PCR) to make copies of portions of the ABO gene.
🕑: 02:00 PM - 06:00 PM
Session 2
Info: In this session, you'll explore how restriction enzymes work like molecular scissors to cut DNA at precise locations. By targeting specific sites in your ABO gene, we can detect genetic differences that help determine your blood type.
Event Venue & Nearby Stays
Genspace, 132 32nd Street, Brooklyn, United States
USD 135.23 to USD 215.26












